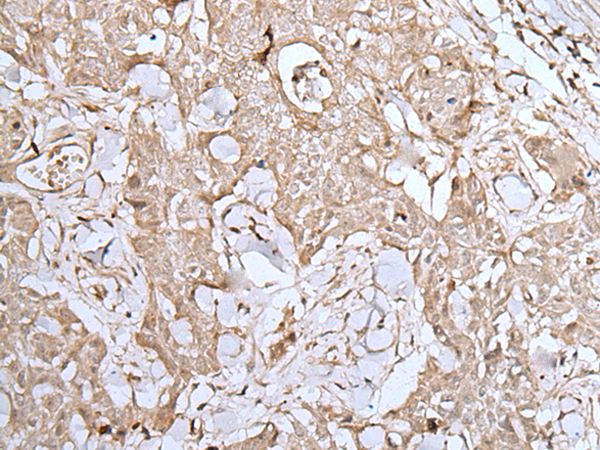

中文名稱(chēng): 兔抗DUSP3多克隆抗體
|
Background: |
The protein encoded by this gene is a member of the dual specificity protein phosphatase subfamily. This gene maps in a region that contains the BRCA1 locus which confers susceptibility to breast and ovarian cancer. Although DUSP3 is expressed in both breast and ovarian tissues, mutation screening in breast cancer pedigrees and in sporadic tumors was negative, leading to the conclusion that this gene is not BRCA1. |
|
Applications: |
ELISA, WB, IHC |
|
Name of antibody: |
DUSP3 |
|
Immunogen: |
Synthetic peptide of human DUSP3 |
|
Full name: |
dual specificity phosphatase 3 |
|
Synonyms: |
VHR |
|
SwissProt: |
P51452 |
|
ELISA Recommended dilution: |
5000-10000 |
|
IHC positive control: |
Human lung cancer and human brain |
|
IHC Recommend dilution: |
25-100 |
|
WB Predicted band size: |
20 kDa |
|
WB Positive control: |
Human fetal liver tissue |
|
WB Recommended dilution: |
200-1000 |

購(gòu)物車(chē)
購(gòu)物車(chē) 幫助
幫助
 021-54845833/15800441009
021-54845833/15800441009
